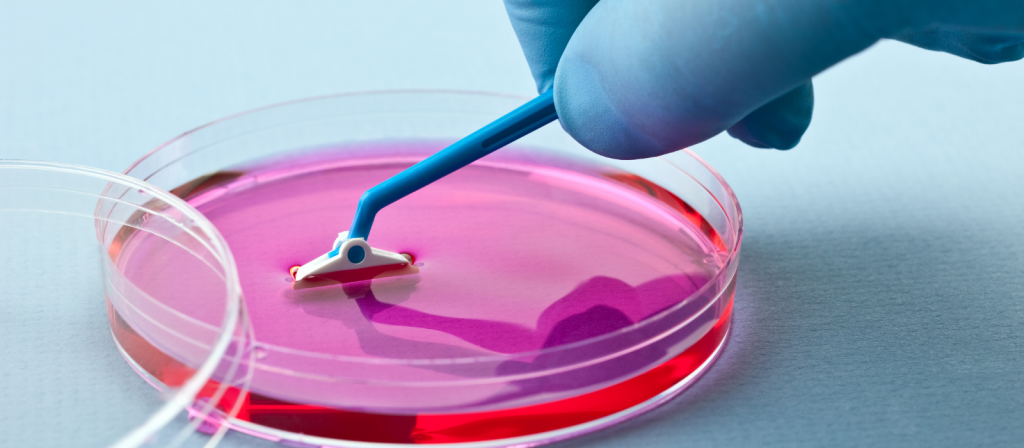

Guia Completo Sobre Meio de Cultura para Fungos: Importância e Aplicações
No mundo da microbiologia, o meio de cultura para fungos desempenha um papel crucial. Este post é dedicado a explorar a importância do meio de cultura para fungos, sua composição, tipos e aplicações em diferentes campos. Vamos mergulhar no fascinante mundo dos fungos e entender como o meio de cultura apropriado é essencial para seu crescimento e estudo.
O Que é Meio de Cultura para Fungos?
Meio de cultura para fungos refere-se ao substrato ou à mistura de nutrientes que promove o crescimento, a reprodução e a sobrevivência dos fungos em um ambiente controlado. Esses meios podem ser sólidos ou líquidos e são fundamentais para o estudo de fungos em laboratórios.
O meio de cultura para fungos é essencialmente um preparado nutricional que fornece todas as condições necessárias para o crescimento e desenvolvimento de fungos em um ambiente laboratorial. Este meio pode ser sólido ou líquido e é especificamente formulado para suportar as necessidades únicas dos fungos, que podem variar significativamente entre diferentes espécies.
- Características Básicas:
- Nutrientes: Inclui fontes de carbono (como glicose ou maltose), que são essenciais para a energia; fontes de nitrogênio (como peptonas ou aminoácidos) para a construção de proteínas; e outros elementos como fósforo, enxofre, vitaminas e minerais que são cruciais para o crescimento fúngico.
- pH: Geralmente, o meio de cultura para fungos é mantido em um pH ligeiramente ácido, ideal para a maioria dos fungos.
- Textura: Pode variar de líquido (como caldos) a sólido, sendo este último frequentemente solidificado com a adição de agentes gelificantes como o agar.
- Especificidade:
- Alguns meios de cultura são “seletivos”, projetados para favorecer o crescimento de certos tipos de fungos enquanto inibem outros.
- Outros são “diferenciais”, contendo indicadores que mudam de cor ou aspecto em resposta a certas características metabólicas dos fungos.
- Finalidade:
- O meio de cultura para fungos é utilizado para isolar, identificar e manter culturas fúngicas para pesquisa e diagnóstico.
- Em ambientes clínicos, é fundamental para identificar patógenos fúngicos causadores de doenças.
- Em pesquisas científicas, permite o estudo do comportamento, reprodução e genética dos fungos.
Em resumo, o meio de cultura para fungos é uma ferramenta indispensável na microbiologia e na biotecnologia. Ele fornece um ambiente controlado e nutricionalmente balanceado, crucial para estudar e compreender os fungos, sejam eles benéficos ou patogênicos.
Composição do Meio de Cultura para Fungos:
- A composição do meio de cultura para fungos varia de acordo com o tipo de fungo que se deseja cultivar. Geralmente, contém fontes de carbono (como glicose), nitrogênio, vitaminas, minerais e, em alguns casos, antibióticos para suprimir o crescimento bacteriano.
Exemplo de meios de cultura para fungos
Existem diversos tipos de meio de cultura para fungos , cada um com características específicas para atender a diferentes necessidades de pesquisa e diagnóstico. Aqui estão alguns exemplos comuns:
- Ágar Sabouraud Dextrose (SDA):
- É um dos meios mais comumente usados para o cultivo de fungos, especialmente leveduras e dermatófitos.
- Contém dextrose como fonte de carbono, peptona como fonte de nitrogênio e agar para solidificação.
- Tem pH ácido, o que inibe o crescimento de muitas bactérias.
- Ágar Batata Dextrose (PDA – Potato Dextrose Agar):
- Este meio é frequentemente usado para o cultivo de fungos filamentosos e leveduras.
- Consiste em extrato de batata e dextrose, que fornecem nutrientes abundantes para o crescimento fúngico.
- O PDA é útil para observar características morfológicas, como a pigmentação e a formação de esporos.
- Meio Czapek-Dox:
- É um meio de cultura bastante específico, usado principalmente para estudos de ascomicetos e outros fungos filamentosos.
- Contém nitrato de sódio como fonte de nitrogênio, além de açúcares, sais minerais e outras fontes de nutrientes.
- Este meio é útil para estudos de metabolismo fúngico e diferenciação de espécies.
- Meio de Cromogar Fungos:
- É um meio diferencial e seletivo para o isolamento de leveduras e fungos.
- Contém corantes e agentes inibidores que suprimem o crescimento bacteriano e diferenciam as colônias de fungos por cor.
- Meio RPMI 1640:
- É um meio líquido frequentemente utilizado em ensaios antifúngicos e pesquisas relacionadas à fisiologia fúngica.
- Rico em nutrientes e frequentemente ajustado a um pH de 7.0 para o crescimento de fungos patogênicos humanos.
Estes meio de cultura para fungos são essenciais para o cultivo e estudo de fungos em laboratórios de microbiologia e biotecnologia, permitindo aos pesquisadores e profissionais de saúde identificar espécies de fungos, testar sua sensibilidade a antifúngicos e estudar suas características morfológicas e fisiológicas.
Importância do Meio de Cultura para Fungos na Pesquisa:
- O meio de cultura para fungos é vital para pesquisas em biologia, medicina e agricultura. Permite o estudo detalhado das características dos fungos, incluindo seu ciclo de vida, metabolismo e patogenicidade.
Aplicações do Meio de Cultura para Fungos:
- Medicina: Vital para identificar fungos patogênicos em amostras clínicas.
- Agricultura: Auxilia na pesquisa de fungos que afetam as plantações.
- Indústria Alimentícia: Importante para o controle de qualidade e a pesquisa de fungos que podem contaminar alimentos.
Conclusão:
O meio de cultura para fungos é uma ferramenta indispensável na microbiologia. Seu uso adequado permite avanços significativos em várias áreas, desde a descoberta de novos medicamentos até a proteção de culturas agrícolas. A escolha do meio de cultura correto é fundamental para o sucesso de qualquer estudo envolvendo fungos.
Está interessado em explorar mais sobre o fascinante mundo dos fungos e a importância dos meios de cultura? Se você é um estudante, pesquisador, profissional de laboratório ou simplesmente um entusiasta da microbiologia, nós temos as informações e os recursos que você precisa. Junte-se à nossa comunidade para receber atualizações regulares, participar de workshops e acessar uma variedade de recursos educacionais. Não perca a oportunidade de aprofundar seus conhecimentos sobre meios de cultura para fungos e suas aplicações. Solicite seu orçamento em meio de cultura para fungos.
AVISO DE DIREITOS AUTORAIS: Todo o material deste blog, sendo proibida toda e qualquer forma de plágio, cópia, reprodução ou qualquer outra forma de uso.
Qualquer dúvida técnica sobre os equipamentos contidos no portfólio SPLABOR, entre em contato com o Departamento de Vendas (sp@splabor.com.br)

A Splabor é uma empresa líder no ramo de fabricação de equipamentos para laboratório, especializada em oferecer uma ampla variedade de equipamentos para laboratórios, materiais e produtos para laboratório de alta qualidade.